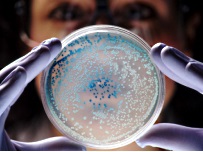

Возможно, что содержащиеся в нашем кишечнике бактерии являются ключом к долголетию и здоровой жизни. Эксперты из Вашингтонского университета в США выяснили, что от этих микроорганизмов зависит вес человека и риск стать жертвой разных болезней.
Возможно, что содержащиеся в нашем кишечнике бактерии являются ключом к долголетию и здоровой жизни. Эксперты из Вашингтонского университета в США выяснили, что от этих микроорганизмов зависит вес человека и риск стать жертвой разных болезней.
У каждого человека настолько индивидуальный набор микроорганизмов в кишечнике, что его можно назвать "бактериальным удостоверением личности", как установили американские ученые. Исследователи подчеркивают, что их работа не дала ответ на вопрос, способен ли человек влиять на свой микробиом (совокупность всех микробов в организме). Но зато удалось выяснить, что тщательный разбор содержания бактерий в кишечнике (к примеру, с помощью анализа стула) может стать непременной основой для любого осмотра врачей общей практики в недалеком будущем.
Сами ученые брали анализы стула у 37 здоровых американцев в течение 5 лет. Это позволило разработать новый тип генетического тестирования для отслеживания разных видов бактерий. Тесты выявили наличие уникального набора микроорганизмов у каждого человека, хотя близкие родственники и обладали схожими типами бактерий. При этом сами колонии бактерий в кишечнике менялись редко - более 70% штаммов оставались такими же через год, а 4 года спустя отмечались незначительные изменения.
Но можно ли активно изменять баланс бактерий? 4 добровольца, страдавших от ожирения, перешли на другую диету. У них бактерии кишечника менялись более часто, и ученые заметили, что существовали определенные группы микроорганизмов, которые быстро развивались или же сокращались во время диет. Однако, скорей всего, эти изменения были больше связаны с реальной потерей веса, а не с ингредиентами диетических молочных коктейлей. Так что утверждать о том, что с помощью определенных бактерий можно помочь человеку вернуть здоровый вес, пока еще преждевременно - требуются новые исследования.
 Дзебак Владимир
РОЗДУМИ ПРО НАДВАЖЛИВЕ або ЧОМУ НАШІ ОЛІГАРХИ СТАЛИ МОГИЛЬЩИКАМИ НИНІШНЬОЇ УКРАЇНИ
Дзебак Владимир
РОЗДУМИ ПРО НАДВАЖЛИВЕ або ЧОМУ НАШІ ОЛІГАРХИ СТАЛИ МОГИЛЬЩИКАМИ НИНІШНЬОЇ УКРАЇНИ

Возможно, что содержащиеся в нашем кишечнике бактерии являются ключом к долголетию и здоровой жизни. Эксперты из Вашингтонского университета в США выяснили, что от этих микроорганизмов зависит вес человека и риск стать жертвой разных болезней.
Возможно, что содержащиеся в нашем кишечнике бактерии являются ключом к долголетию и здоровой жизни. Эксперты из Вашингтонского университета в США выяснили, что от этих микроорганизмов зависит вес человека и риск стать жертвой разных болезней.